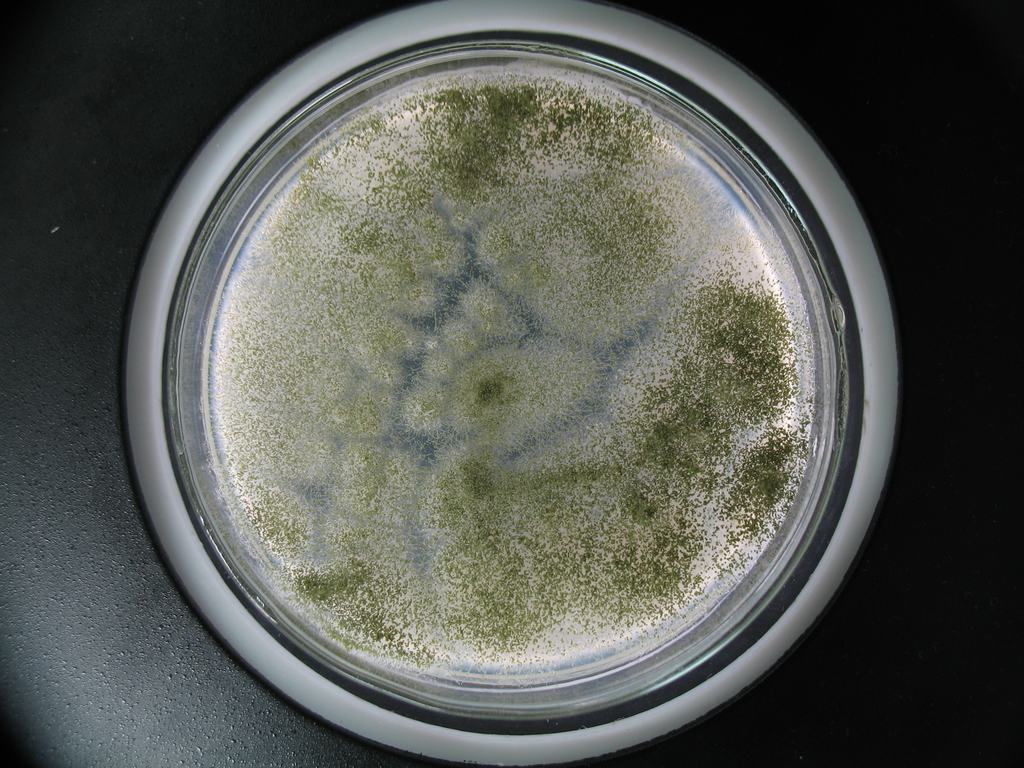
p data-id="gnviawfphr">米根霉(rhizopus oryzae went et pr.geerl.
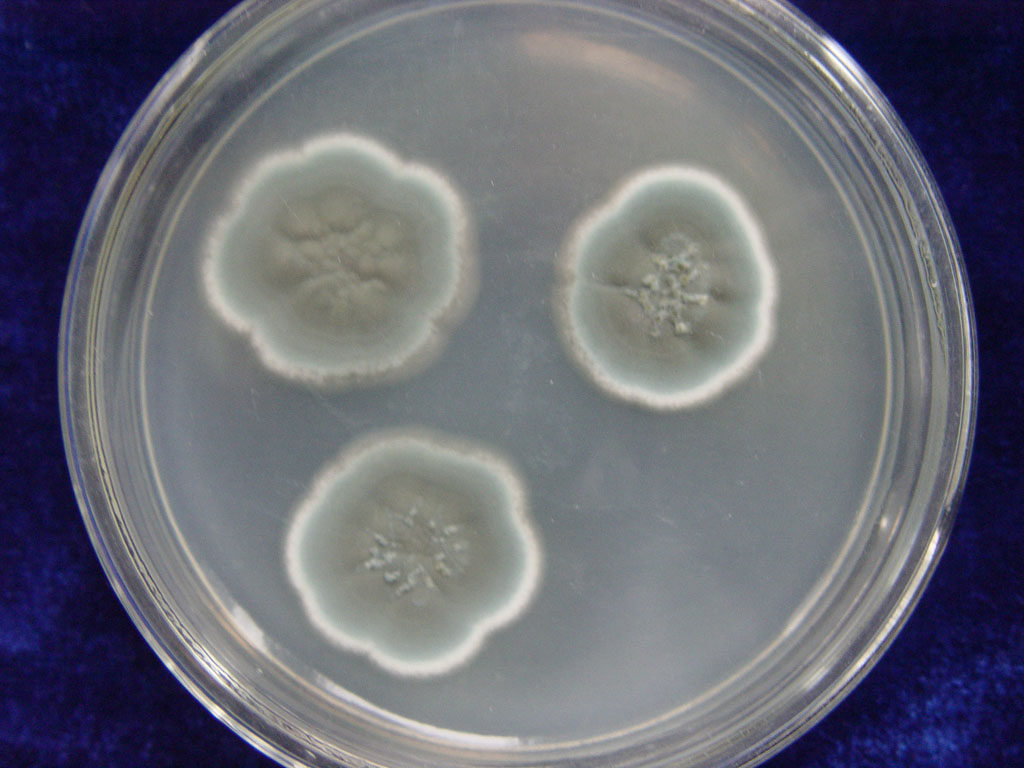
p>匍枝根霉(拉丁名:rhizopus stolonifer)亦称黑面包霉,是一种常见的

rhizopus

游美国红杉树 国家公园
图片尺寸1200x2042
加利福尼亚红杉国家公园夏季的巨型红杉树
图片尺寸700x467
加利福尼亚州红杉国家公园的巨型红杉树
图片尺寸682x1023
rhizopus stolonifer, fungus. bread mold. angelika reichmann
图片尺寸640x541
令人惊叹,世界上有3200年历史的大树!
图片尺寸666x1000
红杉,加利福尼亚,红木森林,巨红杉树,树冠正版图片素材下载
图片尺寸408x612
参天大树
图片尺寸990x660
根霉属 rhizopus
图片尺寸528x464
p> b>根霉属(rhizopus) /b>原接合菌门,现 a target="_blank" href="
图片尺寸350x276
红杉,加利福尼亚,红木森林,巨红杉树,树冠正版图片素材下载
图片尺寸612x408
p data-id="gnviawfphr">米根霉(rhizopus oryzae went et pr.geerl.
图片尺寸1024x768
p>匍枝根霉(拉丁名:rhizopus stolonifer)亦称黑面包霉,是一种常见的
图片尺寸1024x768
根霉菌(rhizopus)分布广,约10种以上.
图片尺寸295x277
此菌和面包霉(rhizopus stolonifer)类似,具有白色棉絮状的菌丝,上面
图片尺寸768x1310
zygosporangium- phylum rhizopus | flickr – 相片分享!
图片尺寸500x375
rhizopus sporangia 5 | flickr – 相片分享!
图片尺寸500x374
platypus是什么意思
图片尺寸800x1333
红杉树公园
图片尺寸1280x960
p data-id="gnviawfphr">米根霉(rhizopus oryzae went et pr.geerl.
图片尺寸682x512
tapeta rhodesian ridgeback
图片尺寸2160x1440